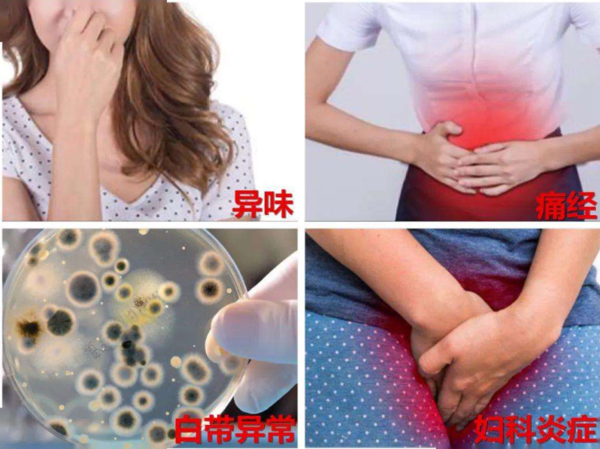

女性应该如何做好产后恢复?
前日是“三八”妇女节,在这个呼吁关爱女性的日子,女性的产后健康一直是备受关注的话题。产后如何恢复?心理健康如何调节?不只是生育一孩的产妇,有不少生育二孩的女性已达到高龄产妇的标准,生育的风险还会相应增加。由此出现的产后恢复难度增大、产后心理健康等问题,都非常值得关注。
产后心理健康问题需重视
十月怀胎迎接新生命,可在这之后,部分妈妈的问题就来了。在孩子出生后,她们变得越来越沉默、忧郁,有的甚至脾气变得很坏,这些都可能是产后抑郁症带来的影响。不少人认为产后抑郁症常会在新手妈妈身上出现,已有生育经验的二孩妈妈受影响的机会较小。但事实上,无论第几次生育,都需要注意产后心理健康问题的出现。
佛山市第三人民医院临床心理科主任徐彩霞介绍,根据相关研究,约有50%~80%的女性,在分娩后的3~7天会开始出现情绪不稳定、失眠、食欲下降、注意力不集中、头痛、易发怒、苦恼等情况。大多数人能在产后10~14天缓解,但也约有3%~6%的女性在孕期,或产后的数周甚至数月内经历一次重性抑郁发作。
徐彩霞表示,产后抑郁的主要表现为情绪低落,消沉沮丧,精力、体力不支,疲惫而无力照顾婴儿,哭泣、忧伤、极度焦虑,后悔自责,强烈的无助感、孤独感,严重的甚至觉得生活毫无意义,出现幻觉妄想,甚至出现极端想法或行为。
“生育一孩或二孩的女性,都可能会出现产后抑郁症的表现。”徐彩霞建议,如产后2周时间内,出现多项产后抑郁症相关症状且一直难以自我调节时,产妇及家人都应引起重视,及时寻求专业帮助。
她提醒,要想预防产后抑郁,最好方法就是多跟其他人交流。除了向丈夫、家人、朋友倾诉,还可参加一些线上的孕产妇互助群,大家相互鼓励、排忧解难。产前可前往正规的孕妇学校,了解更多孕期产后的知识,还可以跟其他聊得来的孕妈成为朋友。此外,身体恢复后适当运动也可预防产后抑郁,如健身操、跑步、瑜伽等。
产后42天到一年内是恢复黄金期
“每一位产后的女性,我们都建议接受专业规范的产后康复,这对于女性长久的身体健康具有重要意义。”佛山市禅城区中心医院女性康复专科主任文红蕾表示,生育小孩对于女性会造成身体机能的损伤,产后都需要开展一定的产后恢复措施,但不少女性都缺乏科学的产后恢复意识。
文红蕾指出,临床上不少女性产后没有进行正确的产后恢复,对于身体带来的影响可能不会马上显现,而是产后数年甚至更长时间才会逐渐浮现。如较常见的女性漏尿问题以及各种疼痛症状。如不在产后的“黄金恢复期”采取相应恢复手段,可能随着年龄的增长,逐渐出现并加重,也增加了后期治疗的难度,尤其是生育二孩的女性。
文红蕾建议,产后42天到一年内,都是开展产后恢复的黄金时期,这一时段内开展专业规范的产后恢复治疗,可收获较好的效果。常见的产后恢复手段除了合理均衡饮食及注意休息,还有腹部、臀部、腿部、盆底肌等各部位的锻炼。但需要注意的是产后恢复指导应寻求正规的医疗机构帮助,在专业指导下进行。切勿盲目听信民间偏方或通过未经专业认可的网上教程自行开展。
产后应加强肌肤护理
对于不少生育小孩的女性来说,如何应对“颜值”变差也是她们非常关心的话题。佛山市妇幼保健院皮肤科易娟娟主治医师表示,女性产后皮肤自然衰老速度会比孕前加快33%~48%,孕产期更相当于皮肤10~13年的自然衰老过程。产后可以说是女性一生中最重要的肌肤护理阶段。
常见的皮肤问题包括皮肤变得粗糙干燥,甚至出现粗糙脱皮、局部水肿等;约两成妈妈在孕后面颊会长褐斑;孕期激素波动,疏于护理,可能让皮肤的屏障功能受损,皮肤敏感性增加,出现皮肤过敏、青春痘等;部分女性产后坐月子过度进补,营养过剩,还可能给皮肤的新陈代谢造成负担,容易使肌肤长脂肪粒。
易娟娟建议,产后应首先注意做好防晒,并适当使用防晒产品;同时注意饮食平衡,避免过度进补;多喝水和吃适量的水果蔬菜,可多吃富含维生素C和E的食品,如黄瓜、番茄等。饮食方面可适量摄入优质蛋白,特别是胶原蛋白,如牛奶、鸡蛋、鱼类等食品,并保持乐观情绪和充足睡眠。
洗脸应选择温和无刺激洗面奶,用37℃左右温水洗脸。干性皮肤洗脸不宜太频,每天早晚洗脸即可,油性皮肤可适当增加洗脸频次。正确选择补水的护肤品,早晚使用,并在重点干燥区内轻轻加以按摩,及时给肌肤补水。适当使用纯天然温和洁面、护肤产品,不要过多使用美白和高营养产品,以免堵塞毛孔形成脂肪粒、暗疮等。

有数据统计
每年都做妇科检查的女性只占约49%
这其中过半的人做妇检间隔都在1年以上
很大程度上致使各种妇科病的发生率连年攀升
有些人因心生畏惧而拒绝妇科检查
有些人认为年纪轻不用做
也有些人不知道该做哪些妇科检查……
其实
定期的妇科检查不仅能及时掌握健康状况
还能早发现妇科疾病,及时治疗
无形中成为女性的一道“护身符”。
佛山市卫健委审核批准的
二级妇产专科医院
佛山都市妇产医院
特别推出38、88、268元女性健康体检活动
活动时间
3月1日-3月31日
名额有限,先到先得!



关于我们:
佛山都市妇产医院是经卫生部门批准设立的二级妇产专科医院,是佛山市城镇职工/居民/生育医疗保险定点医院,异地(跨省)新农合医保定点医院,是广东省诚信医院建设单位,也是有《医疗机构许可证》、《母婴保健技术服务执业许可证》的,为妇婴提供产科、妇科、儿科及生殖健康与不孕症等高品质医疗服务的专业妇产医院。
医院地址:佛山火车站旁
乘车路线:佛山市内乘坐100、101、102、105、106、107、112、114、115、116、122、124、127、134、G12、G14等到佛山火车站即可到达。
佛山都市妇产医院节假日不休息,照常接诊。
健康咨询&预约热线:4000-138-120
近日,佛山海关驻南海办事处共对2批总重约240吨的禁止进口固体废物进行退运出境。
据佛山海关介绍,这2批进口的粗制氧化锌是由锌灰、锌浸出渣、瓦斯泥等含锌原料经高温溶解蒸发后生成的氧化金属粉(主要成分为氧化锌),混杂大量粉尘、煤灰以及未氧化的金属,未经仔细分拣进境,其处理过程将会造成较严重的环境污染。
佛山海关提醒,进口企业应严格遵守《中华人民共和国货物固体废物污染环境防治法》及相关固体废物法律法规的规定,落实主体责任,确保进口货物合法。
微信
新浪微博
QQ空间
QQ好友
豆瓣
Facebook
Twitter


